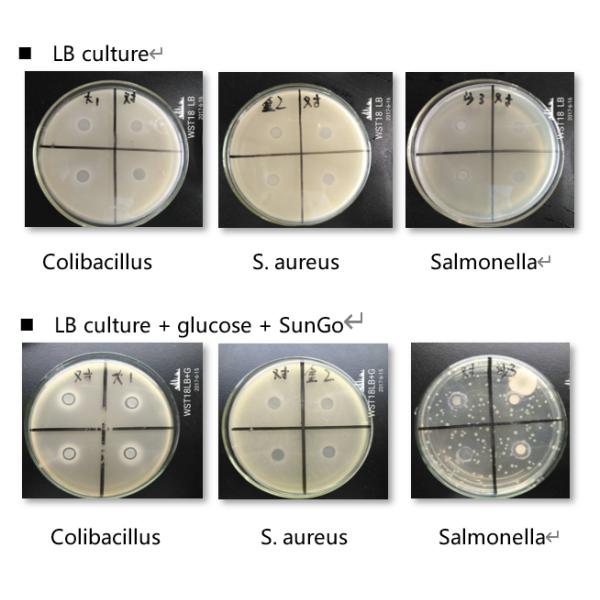

SunGo 5000, новое поколение и термостабильная оксидаза глюкозы используемые как антибиотический заменитель
Оксидаза глюкозы, также известная как notatin, сделанный секретным энзим синтезированный большей частью в нескольких видов насекомых и грибков, который окисляет глюкозу в glucolactone, преобразовывая кислород в перекись водорода в процессе. В наше время, оксидаза глюкозы широко использована как добавки питания для замены на антибиотики в питании. SunGo 5000 произвело предварительным напряжением в мире, и выполняет превосходные каталитические эффективность и термоустойчивость сразу технологией microencapsulation развития и обездвиживания. что может заблокировать пролиферацию патогенов и улучшить кишечное здоровье, и усиливает животную невосприимчивость.
Противобактериологическое влияние (диаграмма 1)
Спецификация таблицы 1. SunGo 5000
| Имя продукта | SunGo 5000 | ||
| Деятельность, U/g | 5000 | Форма | Порошок |
| Активный ингредиент | Оксидаза глюкозы | Несущая | Кукурузный крахмал |
| Возникновение | Желтый цвет | Запах | Undetectable |
| Дозировка | питание 100-300g/T | Применение | Питание птицы/свинeй/аквакультуры/жевания жвачки |
| Место происхождения | Ухань, Китай 430206 | Срок годности при хранении | 12 месяца |
| Аттестация | FAMI-QS, ISO9001, ISO22000 | Согласно | Q/XHY 05-2018 |
Преимущества
Уничтожьте кислород в GIT, заблокируйте рост аэробных бактерий, и запланируйте к здоровой кишечной микрофлоре;
Катализируйте реакцию которой производящ глюконовую кислоту, уменьшите пэ-аш желудочно-кишечного тракта, повысьте пищеварение, и уменьшите пролиферацию патогенического;
Используйте как замещение некоторых антибиотиков для того чтобы обработать гастрит и понос птицы glandular;
Усильте невосприимчивость и увеличьте функцию обороны;
Улучшите качество питания, расширьте срок годности при хранении, улучшить удобоваримость питания, и улучшите проведение роста.
Пакет
25 kg/bag
Срок годности при хранении и хранение
12 месяца, сохраненного в крутом (<25>